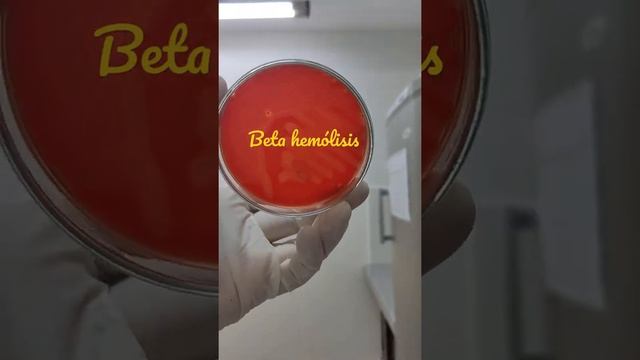
Beta hemólisis en Agar Sangre смотреть онлайн

Автор / Канал: Лекторский райский райский сад Страница 8

PAUKŠČIAI NELAISVĖJE: Papugėlės visaip žavi pirkėjus kad tik ištrukti į LAISVĘ

10 стыдных вопросов о смерти | Подкаст Лайфхакера

THE BEST AGING ULTRA! ULTRA GOGETA BLUE IS STILL DOMINANT! (Dragon Ball Legends)

4-28-2024 | Fifth Sunday of Easter

I'll Never Let You Leave ~ ♡ Yandere Girlfriend Psychologically Tortures You (F4A)

Линия выравнивания мешков/Bag flattener line

перед - ܩܕ݇ܡ - qam - before

Chromosomes revelation in the book of Genesis 🧬🧬🤯🤯

Bad Boy-BIGBANG Is Back!-download link:http://adf.ly/5raQM

Охота на Селезня с подсадной уткой 2024г на СЕВЕРНОМ УРАЛЕ #3

inmates grow sage brush

Жүрек ақаулары

Lego Spaceship: Galactic Mediator Review (Classic)

Стандарт Kurd (D) + KORG Wavedrum (IMAGO Handpan) Ханг/Хендпан/Хангдрам/Пантам/Хэндпан/Hang

Reverse Bloom's Taxonomy - Right or Wrong
![[Sound Space] Hayware - Insight (speed -) 99.06% смотреть онлайн [Sound Space] Hayware - Insight (speed -) 99.06% смотреть онлайн](https://pic.rtbcdn.ru/video/2024-11-26/d5/10/d510acefc622d72c2855e19ec8ff1f54.jpg)
[Sound Space] Hayware - Insight (speed -) 99.06%

Новости МТМ - Цветы жизни - 01.06.2012
Beta hemólisis en Agar Sangre

😱КАК ПРОЙТИ АЙРУЛ БЕЗ ЧАДОВ? ПРОХОЖДЕНИЕ БЕЗ СЕРДЦА ДАЮЩИХ МАЛЫШЕЙ!

Активная Сыворотка Дермин Dermyn Active Serum

patroana de la strehaia beata de fericire dans tribal

#e'clat superior#Fadeout pigment correcting serum honest review|#acne#age spots fadout serum|

Зона накопления WSA

【Rainych】Hotaru no Hikari - Ikimono Gakari『Naruto Shippuden OP 5』 (cover)
За каждым успешным каналом стоит личность, идея и сотни часов кропотливого труда. Если вы здесь, значит, автор «Лекторский райский райский сад» уже сумел зацепить ваше внимание своим уникальным стилем или подачей. А мы на RUVIDEO позаботились о том, чтобы вы могли изучить весь архив его работ в максимально комфортных условиях — без лишней суеты и преград.
Почему за работами канала «Лекторский райский райский сад» так интересно наблюдать? Всё просто: это честный контент, который находит отклик в сердцах зрителей. На нашем ресурсе вы можете смотреть онлайн все видео любимого автора бесплатно и в хорошем качестве. Нам важно, чтобы вы видели каждую деталь и слышали каждый нюанс, поэтому мы используем только стабильные плееры из открытых источников Rutube.
Следите за новинками канала, пересматривайте старые шедевры и открывайте для себя новые грани творчества «Лекторский райский райский сад». Мы постоянно обновляем ленту, чтобы у вас под рукой всегда были самые свежие выпуски. Никаких сложных регистраций — только вы и творчество, которое вдохновляет. Приятного вам путешествия по миру авторского контента на RUVIDEO!
Видео взято из открытых источников Rutube. Если вы правообладатель, обратитесь к первоисточнику.